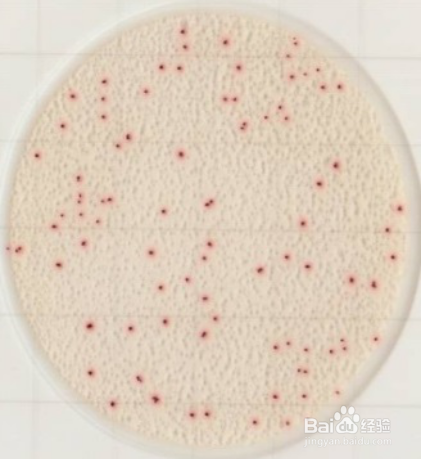
手部及工器具涂抹实验方法

手部及工器具涂抹实验方法
1、取出涂抹棒并对每根涂抹棒进行编号标记

2、拧开涂抹棒瓶盖,并挤掉一部分棒头的水分

3、在10*10cm的范围内对被涂抹表面进行涂抹取样(手部涂抹时手掌面和手背面都要涂抹完全)

4、取样完毕后将涂抹棒放回管内,拧好瓶盖并振荡3-5次使管内溶液混匀

5、取一片菌落总数测试片,将涂抹棒瓶盖上面盖板打开,倒转涂抹棒,并向测试片中央滴入1ml样液(看管壁刻线或准确滴入20滴)

6、将测试片盖膜盖好,放入培养箱进行培养48小时,根据测试片中长出菌落计数。
声明:本网站引用、摘录或转载内容仅供网站访问者交流或参考,不代表本站立场,如存在版权或非法内容,请联系站长删除,联系邮箱:site.kefu@qq.com。